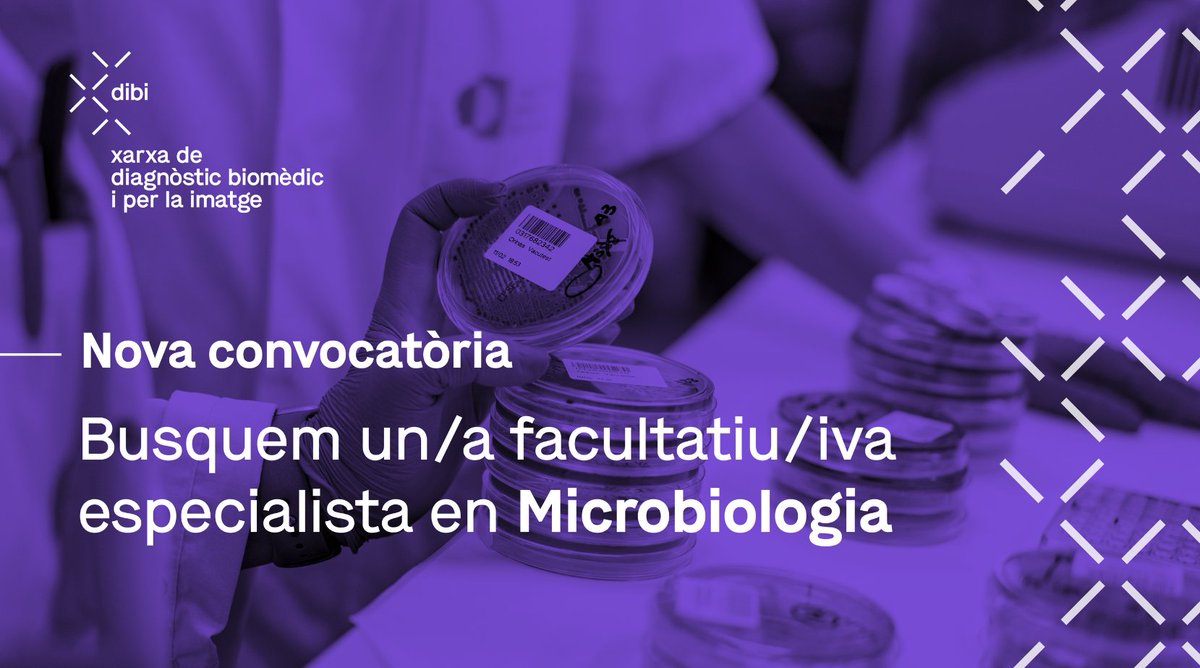

Dibi· Xarxa de diagnòstic biomèdic i per la imatge
@dibixarxa
Dibi és una xarxa pública de serveis integrats de diagnòstic biomèdic i per la imatge que s'adreça a hospitals i centres de salut. #XarxaDibi
ID: 1485935728743919617
https://dibi.cat 25-01-2022 11:22:11
878 Tweet
224 Followers
375 Following

L’Hospital del Mar aplica una innovadora tècnica per al tractament del #càncer de pell #nomelanoma Fa servir un #radioisòtop i permet evitar l’abordatge quirúrgic #medicinanuclear #dermatologia Dibi· Xarxa de diagnòstic biomèdic i per la imatge Enric Fernández-Velilla Joe Maiques hospitaldelmar.cat/ca/noticies/vi…


🟣 Amb motiu del #DiaMundialAlzheimer, compartim les conclusions de l’estudi #PLASMAR Elaborat per Hospital del Mar, Barcelonaβeta Brain Research Center i amb la col·laboració del Laboratori de Referència de Catalunya (LRC), integrat a la #xarxadibi ▶️ tuit.cat/9t8Fp


Si voleu saber més sobre la innovadora tècnica que aplica l'Hospital del Mar en el tractament del #càncerdepell #nomelanoma, només cal que vegeu aquest vídeo 🎥 #dermatologia #medicinanuclear Dibi· Xarxa de diagnòstic biomèdic i per la imatge Enric Fernández-Velilla Joe Maiques hospitaldelmar.cat/ca/noticies/vi…

🏥 A #xarxadibi reafirmem el nostre compromís amb la qualitat renovant el laboratori de l'Hospital del Mar centre Esperança. La millora inclou terres, mobiliari i instal·lació elèctrica. També s'ha actuat a l'àrea d'extraccions de l'Hospital del Mar. ℹ️ tuit.cat/paOcM


🔔 Ets especialista en #AnàlisisClíniques o #Bioquímica Clínica? 🏥 Uneix-te al laboratori de l’Hospital del Mar, un projecte amb molta projecció. 📝 Convocatòria i inscripció: tuit.cat/9o6Wn


📢 ¿Eres especialista en Análisis Clínicos o #Bioquímica Clínica? ¡Te estamos buscando! 🏥 Únete al equipo de laboratorio del Hospital del Mar ▶️ Convocatoria e inscripción en tuit.cat/9o6Wn


A #EnBonesMans d'Onda Cero Catalunya 📻, en Robert Calvo 🎙️ entrevista el Dr. Pedro Plaza per conèixer els detalls de la nova tècnica per al tractament del #càncer de pell no melanoma #dermatologia #medicinanuclear Dibi· Xarxa de diagnòstic biomèdic i per la imatge Enric Fernández-Velilla Joe Maiques ondacero.es/emisoras/catal…

🔬 #dibimatge | Secció histològica d'un carcinoma mucinós, realitzada pel Servei d’Anatomia Patològica de l'Hospital del Mar, integrat a #xarxadibi S'observen cèl·lules tumorals en nius, envoltades de material mucoide. Aquestes lesions són més freqüents en dones d'edat avançada.


A farmacosalud.com expliquen els detalls de la innovadora tècnica que aplica l'Hospital del Mar en el tractament del #càncerdepell #nomelanoma #dermatologia #medicinanuclear Dibi· Xarxa de diagnòstic biomèdic i per la imatge Enric Fernández-Velilla Joe Maiques farmacosalud.com/un-novedoso-ge…


🟣 Vols créixer professionalment en un entorn compromès amb la qualitat assistencial? Suma’t a la #xarxadibi! Busquem un/a facultatiu/va especialista en #Microbiologia per incorporar-se a Corporació de Salut del Maresme i la Selva ▶️ Inscripcions a tuit.cat/3nr1M

🟣 ¿Quieres crecer profesionalmente en un entorno comprometido con la calidad asistencial? ¡Súmate a la #xarxadibi! Buscamos un/a facultativo/a especialista en #Microbiología para incorporarse a Corporació de Salut del Maresme i la Selva ▶️ Inscripciones en tuit.cat/3nr1M


VII Jornada científica del grup espanyol EURECCA de càncer esofagogàstric (GEECEG) al Colegio de Médicos de Sevilla El Dr. Manuel Pera va dirigir la jornada, que va comptar amb el Professor John Reynolds, St James's Hospital Trinity College Dublin La Dra. Mar Iglesias va dirigir la reunió de patòlegs





🔎 Busquem un/a tècnic/a superior en #laboratori clínic i biomèdic de reforç per a substitucions per al laboratori d’Anàlisis Clíniques de Mas Blau. 📝 Envia el teu CV a 📩 [email protected] #Feina #OfertaLaboral #OfertaDeFeina #Treball


🤖 Presentem #dibibot al darrer seminari del Servei d'#Epidemiologia i Salut Pública d'HMar Research Institute Amb IA generativa s'ha dissenyat per donar resposta a les incidències de la fase preanalítica del laboratori i millorar el #RightCare Coneix #dibibot ➡️ tuit.cat/8lowf


🗣️ El Dr. Jorge Gorrín, Cap del Laboratori Core de la #xarxadibi, ha participat en el 66è Congrés #SEEN de Sociedad SEEN a Granada. Ha presentat una actualització sobre el diagnòstic i el monitoratge de la hiperplàsia suprarenal congènita. Més info ➡️ tuit.cat/9gvyI
